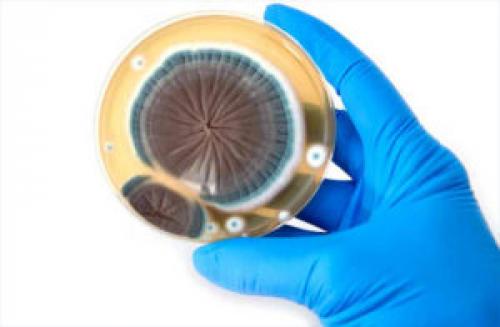
Что такое плесень. Плесень: что такое, какой бывает и почему появляется
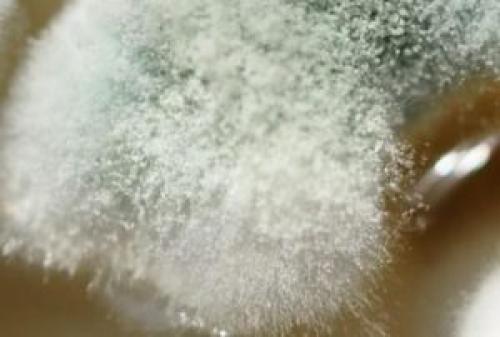
Что такое плесень. Плесень: что такое, какой бывает и почему появляется

Виды плесени. Плесень - один из самых древних живых организмов на земле.
- Виды плесени. Плесень - один из самых древних живых организмов на земле.
- Плесень красного цвета
- Черная плесень
- Виды черной плесени. Черная
- Белая плесень на досках. Как убрать черную плесень на досках (Рекомендации)
- Что такое плесень. Плесень: что такое, какой бывает и почему появляется
- Что такое плесень?
- Какой бывает плесень?
- Черная
- Зеленая
- Розовая
- Белая
- Голубая
- Серая
- Почему появляется плесень?
- Голубая плесень. Голубые сыры
- Виды плесени на хлебе. Опасные виды плесени на хлебе
- Белая плесень
Виды плесени. Плесень - один из самых древних живых организмов на земле.
Она появилась 200 миллионов лет назад и научилась выживать в любых условиях: в радиации, арктических льдах и открытом космосе. Она спасает жизни и способна убить.
Умная плесень.
Помните старый эксперимент, где крыса должна найти правильный путь в лабиринте, чтобы заполучить еду. Так вот, как выяснил японский ученый тошуки накагаки, плесень справляется с этим заданием не хуже . В 2000 году он провел эксперимент, поместив у входа в лабиринт плесневой гриб "Physarum Polycephalum", а на выходе кусочек сахара.
. В 2000 году он провел эксперимент, поместив у входа в лабиринт плесневой гриб "Physarum Polycephalum", а на выходе кусочек сахара.
Плесень сразу же пустила "Ростки" именно в сторону сахара, споры гриба заполняли собой все пространство в лабиринте, раздваиваясь на каждом перекрестке. Как только какой-нибудь из отростков попадал в тупик, он поворачивал обратно и искал путь в другом направлении. Микроскопическому грибу понадобилось всего 4 часа, чтобы заполнить собой все ходы лабиринта и отыскать верную дорогу к сахару.
Но, что самое интересное, когда у уже прошедшего лабиринт грибного мицелия отщипнули кусок и вновь поставили у входа в лабиринт, положив в конце сахар, - один из ростков безошибочно выбрал самый короткий путь к выходу из лабиринта и сахару, а второй просто "Вскарабкался" по стенам лабиринта и пополз по потолку. Таким образом, простая плесень обнаружила не только зачатки памяти, но и способности к нестандартному способу решения задач, что говорит о наличие у гриба интеллекта.
Опасная плесень.
Плесень сопровождает нас повсюду, она огромными колониями обитает в ванных, квартирах, вентиляционных шахтах, и что самое неприятное, в наших холодильниках. Поэтому люди привыкли просто ее не замечать. И зря.
Помимо того, что микроскопический грибок способен уничтожать целые здания, он еще и ядовит для человеческого организма. В процессе роста он вырабатывает вещества, которые поражают легкие, кишечник, кожу. Их споры проникают в дыхательные пути и "Оседают" внутри нас, открывая дорогу бактериям и вирусам. Аллергия - чуть ли не самое безобидное следствие проживания с плесенью в качестве соседа. Микроскопический грибок способен разрушать структуру днк и приводить к раковым заболеваниям.
По словам ученых, плесень и ее яд практически не выводятся из организма. Самой опасной, в данном случае, считается желтая плесень из рода аспергилл, которая "Заводится" на молочных продуктах, рыбе и орехах. Она выделяет опасное вещество афлатоксин, которое накапливается в организме и через 10 лет может стать причиной онкологии печени.
Проклятие тутанхамона.
По крайней мере, в двух загадочных смертях, последующих за открытием археологом Говардом картером нетронутой гробницы тутанхамона, сегодня винят плесень. Оказалось, что в тканях легких мумии все еще жил плесневый грибок аспергиллус Нигер, который может стать смертельным для людей с ослабленным иммунитетом или с поврежденной легочной системой.
Первая жертва "Тутанхамона" - организатор и спонсор раскопок лорд карнарвон еще задолго до обнаружения гробницы попал в страшную автомобильную аварию, в которой повредил легкое. Он от пневмонии спустя некоторое время после посещения гробницы умер. Вслед за ним скончался и другой участник раскопок - Артур мейс, который, по трагичной случайности, был тяжело болен до начала раскопок. Его ослабленная иммунная система стала идеальной средой для проявления смертоносных качеств плесени.
Непобедимая плесень.
Одно из основных и самых опасных свойств плесени является ее вездесущность. Микроскопические грибки способны выживать, без преувеличения, в любых условиях. Они прекрасно чувствуют себя среди арктических льдов, на радиоактивном саркофаге 4-го энергоблока чернобыльской АЭС, и даже в открытом космосе.
Так, в рамках эксперимента "Биориск", который был направлен на исследования влияния условий открытого космоса на живые организмы, три капсулы со спорами плесневых грибов пенициллум, аспергилус и кладоспориум вывели в открытый космос и прикрепили к обшивке орбитальной станции. Результаты были просто ошеломляющие, споры плесневых грибов после полугодового пребывания в открытом космосе не только выжили, но еще и мутировали, став более агрессивными и устойчивыми.
И это еще не рекорд. Исследователи поместили плесень из рода аспергилус фумигатус в пробирку с мощным антигрибковым препаратом. Часть колонии выдержала удар. И это несмотря на то, что шанс выжить у плесени в данных условиях был ровно таким же, как у человека, помещенного в концентрированную серную кислоту.
Плесень и антибиотики.
Пенициллин - первый в мире антибиотик, спасший жизни сотням тысяч военных во время второй мировой войны, впервые был выведен британским бактериологом Александром Флемингом в 1928 году из штамма плесневого гриба вида пенициллум нотатум.
Как и в случае с большинством гениальных открытий, это произошло совершенно случайно. В одной из чашек Петри с бактериями стафилококка, в результате неправильного хранения завелась серо-зеленая плесень. Флеминг с удивлением обнаружил, что не убиваемые колонии стафилококков, унесшие столь много жизней во время первой мировой, вокруг этой плесени просто растворились. Чудо-лекарство, от которого все раны военных затягивались буквально на глазах, было доработано уже во время второй мировой. На вручение нобелевской премии создателям панацеи - Флемингу, чейну и Флори было сказано: "для победы в войне пенициллин сделал больше, чем 25 дивизий! "Благородная" плесень.
Врачи настоятельно рекомендуют - если продукт начал плесневеть, его необходимо выбросить. Простое удаление пораженного участка ни к чему не приведет. Таким образом, если это мягкие фрукты, хлеб или варенье, то грибница, скорее всего, распространилась на весь продукт.
Но не вся плесень, что на продуктах опасна. Существует и съедобная плесень, с помощью которых человечество вот уже несколько веков изготавливает деликатесные голубые сыры и камамбер.
В начале XV века французский король Карл VI дал жителям деревни рокфор монопольное право на производство в местных известняковых пещерах сыра с одноименным названием. Технология практически не изменилась с того времени. Каждую головку сыра, изготовленного из овечьего молока, протыкают длинными иглами насквозь, чтобы в него могли попасть споры плесени. А стабильная высокая влажность и низкие температуры обеспечивают быстрый рост грибов.
Другой популярный продукт, получаемый с помощью плесени - французское вино "Шато д'Икем". Для его изготовления виноград поражают "Благородной Гнилью" - грибком бодритис цинереа, из-за которого кожица ягоды утрачивает герметичность, сам плод сморщивается, но содержимое при этом становится более концентрированным. "Шато д'Икем", любимое вино русской аристократии XIX века, сегодня одно из самых дорогих вин мира.
Плесень красного цвета
Это обыкновенная белая пенициллиновая плесень, которая обретает красный цвет, взаимодействуя с соляным раствором или вином. В процессе выделки поверхность сыров только протирается полученной смесью, внутри самого сыра плесень не образуется.
Черная плесень
Цвет этого вида плесени зависит не только от её вида, но и от стадии развития, а также материала, на котором она произрастает. Как правило, черный цвет имеют следующие штаммы:
Ulocladium — четвертая группа патогенности, поражает не только материалы, но и продукты. Очень требователен к наличию влаги.
Cladosporium — на начальной стадии бесцветен, кроме чёрного, может принимать большой спектр цветов. Наиболее опасен для семян и растений, не требователен к влаге, может развиваться при низких температурах. Наиболее часто встречающийся грибок на открытом воздухе в летнее время. Некоторые виды питаются дизтопливом и горюче-смазочными материалами, отчего получили название керосиновый гриб. Также поражает другие виды материалов. При проведении микологических обследований у нас он находиться на третьем месте по частоте обнаружения, следуя за Penicillium и Aspergillus.
Penicillium — грибы данного семейства играют огромную роль окружающей среде, активно используются в фармацевтике для приготовления лекарств, В пищевой промышленности для приготовления изысканного сыра с белой плесенью. Но некоторые штаммы, такие как Penicillum marneffei и Penicillium spp. относятся к 3 и 4 группе патогенности и представляют существенную опасность для здоровья людей, кроме того, они очень часто встречаются в квартирах.
Alternaria — очень распространённый грибок четвертой группы патогенности. Наиболее часто поражает фрукты и овощи, но может расти и на коже и в дыхательном пути у людей. Иногда имеет серый окрас, насчитывает около 300 штаммов.
Aspergillus — относится к высшим плесневым грибам, и в зависимости от типа относится к 4 и 3 группе патогенности. Этот вид плесени вызывает у людей и животных аспергиллёзы. Сама грибница изначально имеет белый цвет, но ее споры черного цвета. Наиболее часто встречается в помещениях.
Chaetomium — типично окрашен в чёрный цвет. Часто вызывает у людей аллергию . Основную опасность представляет при попадании в пищеварительный тракт. Известны смертельные случаи вызванные этим грибом.
Phoma — четвертая группа патогенности. Практически всегда грибница черного цвета, а споры бесцветны.
Wallemia — окрашен в чёрный цвет, не представляет серьёзной опасности для человека, но относится типу Ксерофилов, то есть может расти в условиях небольшой влажности и высоких температур, что вызывает некоторые проблемы при борьбе с ним.



Виды черной плесени. Черная
Черный цвет угрожающей вам плесени – один из наиболее распространенных «окрасов». К тому же этот вид приводит в панику хозяев квартир и частных домов, ведь такой грибок наиболее заметен на любого рода поверхностях. Однако черная плесень – это не один вид, это целая группа разнообразных подвидов грибка, которые приобретают подобный оттенок на разных этапах своего развития. Огромную роль также играет материал, на котором грибок оседает. Какие конкретно штаммы относятся к черной плесени:
- белая грибница, но споры черного цвета. Появиться может на любой поверхности. Чем вредна для людей? При длительном контакте этот грибок может вызвать аспергиллез – заболевание, одинаково опасное как для людей, так и для животных;

- Phoma – четвертая группа патогенности. Здесь цветовые характеристики прямо противоположные – грибница имеет черный окрас, а непосредственно споры остаются белыми;
- гораздо большую опасность скрывает в себе привычная нам черная плесень, очень часто заселяющая старые дома, пропитанные влагой. Если ее споры попадают в организм человека, он начинает страдать расстройствами пищеварительной системы, а впоследствии — серьезными заболеваниями органов желудочно-кишечного тракта и дыхательных путей;
- еще один вид черной плесени по внешним признакам мало чем отличается от предыдущего, но является практически безвредным для жителей квартир и частных домов. Тем не менее целой проблемой становится необходимость его выведения. Эта плесень распространяется на зараженной поверхности с неимоверной скоростью и угрожает помещениям, даже если учитывать что уровень влажности здесь никогда не бывает действительно высоким;
- среди разновидностей черной плесени попадаются и те грибы, из которых были изготовлены первые антибиотики и те, что на современном этапе используются для производства сыров;
- довольно живучий и распространенный вид грибка и плесени – споры, которые вначале сохраняют светлые оттенки, а затем приобретают насыщенные черные цвета. В большей степени такого рода микроскопические грибы предпочитают открытую местность. К тому же питаются они керосином, дизельным топливом и прочими схожими материалами. Для этого грибка характерна высокая жизнеспособность, они неприхотливы, однако и для людей особой опасностью не отличаются;
- черная плесень может быть и пищевой – на фруктах и овощах вследствие их длительного хранения возникает темный налет. Вполне возможно, что это грибок, который поражает в основном пищевые продукты.

Белая плесень на досках. Как убрать черную плесень на досках (Рекомендации)
Древесина является излюбленным материалом грибковых колоний. Недостаточно обработанная древесина в сауне, бане или деревянная отделка в ванной комнате под действием избыточной влаги быстро теряет свой привлекательный внешний вид. Появившаяся черная плесень на досках практически не удаляется, так как споры проникают глубоко в материал. 
Почему доска чернеет
Причин появления черного грибка на досках предостаточно:
- плохая вентиляция в помещении;
- повышенная влажность;
- резкие перепады температуры;
- образование конденсата;
- некачественная древесина;
- заражение стройматериалов грибковыми колониями;
- длительный контакт с сырым грунтом.
Чем опасна черная плесень на досках? Черный грибок опасен не только быстрым распространением, но и негативным влиянием на людей и животных, которые вынуждены вдыхать споры. Черная плесень на пиломатериалах, которые используются для постройки дома или для внутренней отделки жилых помещений может привести к заражению абсолютно всех поверхностей. При этом поражение может быть настолько серьезным, что потребуется полный демонтаж деревянных конструкций. 
Чем убрать плесень с доски
Как избавиться от черной плесени на досках? Читайте несколько способов выведения грибка с деревянных поверхностей:
- Покрытие дерева разведенным силикатным клеем.
- Медный купорос.
- Обработка содовым раствором и закрепление результата уксусом.
- Раствор серной кислоты с бихроматным калием.Обработка древесины смолой.
- Средство из 50 гр. борной кислоты и килограмма соли, разведенных в 5 литрах воды. Раствор наносится несколько раз.
Существуют и химические средства для удаления грибка с деревянных поверхностей – Биокс, Акватекс, Элкон, Биосепт, Пинотекс. Выбирайте средства, которые бережно удаляют плесень с дерева и не испортят цвет, то есть в их составе не должно быть хлора и перекиси водорода.
С целью профилактики образования грибка рекомендуем провести тщательную термоизоляцию и гидроизоляцию, обработать строительные пиломатериалы противогрибковыми средствами. А внутреннюю отделку из дерева покройте лаком или покрасьте.
Выбирая древесину для последующего монтажа, обращайте внимание на условия хранения пиломатериалов, а также на состояние древесины. Даже одна деревянная деталь, пораженная грибком, может привести к заражению всей партии.
Что такое плесень. Плесень: что такое, какой бывает и почему появляется
Не каждый горит желанием увидеть в качестве своего соседа плесневые образования. Но как много людей вообще знает о том, с чем имеет дело?
Далее будет представлена общая информация о том, что такое плесень, короткое описание разновидностей, а также обязательные условия возникновения и возможные причины появления этих необычных грибов.
Далее будет представлена общая информация о том, что такое плесень, короткое описание разновидностей, а также обязательные условия возникновения и возможные причины появления этих необычных грибов.
Что такое плесень?
Плесень – это простое по структуре «растение» из грибного семейства. Несмотря на свою простоту, оно сложнее бактерий или дрожжей. Если посмотреть на плесень под микроскопом, можно увидеть, что она состоит не из одной клетки, как бактерии, а из множества. Многочисленные клетки плесени образуют собой длинные нити волокон, которые называются гифами.
Плесень – это грибок, а значит, она размножается с помощью спор. Спора – микроорганизм, защищенный прочным покрытием. Споры находятся в состоянии покоя до того момента, пока не попадут в среду, благоприятную для размножения. Споры развиваются тремя разнообразными методами, зависящими от вида микроскопического гриба:
- круглыми участками в пределах сети гифов;
- веществом в мешочке на конце антенны гифа;
- участком, похожим на цепь, на конце антенны гифа.
Можно сказать, что если плесень – растение, то споры – его семена.Одно «растение» производит тысячи спор, которые уносятся потоками воздуха и, усевшись в теплое местечко, размножаются при первой удобной возможности.
Споры плесени находятся везде, но особенно много их в воздухе.
Развивается грибок во влажных темных местах, где много кислорода и повышенная влажность воздуха. Особенно хорошо плесень прорастает, если этот воздух плохо циркулирует, «застаивается».
Еще одна отличительная особенность грибов плесени состоит в том, что они распространяются исключительно на той еде, которая содержит большое количество сахара или кислоты. Именно поэтому плесневые образования часто видят на кислых плодах (яблоки, персики или абрикосы, цитрусовые и др.) и в зимних овощных заготовках (маринованных огурчиках и помидорах, например).
 Какой бывает плесень?
Какой бывает плесень?
Наиболее очевидным различием является цвет плесневых образований. Рассмотрим виды грибка, опираясь именно на него, как на самый простой признак.
Черная
 Наиболее распространенная и самая опасная из всех видов плесени. Обычно появляется в больших количествах на стенах и потолке. С первого взгляда кажется, что пятна одинаковые, но на самом деле они могут принадлежать разным группам. Из всего многообразия подвидов данной плесени самым распространенным считается аспергилл черный. Он представляет особую опасность для человека и животных, поскольку вызывает заболевания, созвучные названию – аспергиллезы. Возможно Вам будет интересно прочитать подробнее — «»
Наиболее распространенная и самая опасная из всех видов плесени. Обычно появляется в больших количествах на стенах и потолке. С первого взгляда кажется, что пятна одинаковые, но на самом деле они могут принадлежать разным группам. Из всего многообразия подвидов данной плесени самым распространенным считается аспергилл черный. Он представляет особую опасность для человека и животных, поскольку вызывает заболевания, созвучные названию – аспергиллезы. Возможно Вам будет интересно прочитать подробнее — «»
Зеленая
 Зеленая плесень (аскомицеты) распространяется преимущественно в органических материалах, почве или компосте. Продуктами, однако, тоже не брезгует, может поселиться в овощах. По внешнему виду эти плесневые грибы напоминают мох насыщенного зеленого цвета с неровной поверхностью.
Зеленая плесень (аскомицеты) распространяется преимущественно в органических материалах, почве или компосте. Продуктами, однако, тоже не брезгует, может поселиться в овощах. По внешнему виду эти плесневые грибы напоминают мох насыщенного зеленого цвета с неровной поверхностью.
Зеленая плесень достаточно быстро распространяется как в зараженном продукте, так и в организме человека, попадая туда вместе с едой. Именно поэтому, увидев зеленое пятнышко на целой буханке хлеба, ее необходимо выбрасывать целиком.
 Розовая
Розовая
Не портит поверхности, как многие другие виды, не оседает на потолке и стенах, и даже не представляет особой опасности для человека (но употреблять еду с ней, конечно, все равно не рекомендуется).
Появляется, в основном, на остатках растительного происхождения и гнилых продуктах (испорченные овощи, фрукты, в редких случаях – крупы, которые неправильно хранились).
 Белая
Белая
Белая плесень (Мукор) почти всегда поражает деревья, комнатные растения и почву, в которой они растут. «Любит» некоторые продукты (сыр, хлеб). Не считается особо опасной, но иногда может поразить какой-либо внутренний орган. Обычно такое происходит редко с людьми, чей организм имеет очень слабые защитные функции. Не так давно мы опубликовали статью — «»
 Голубая
Голубая
Редко появляется в домах, не представляет опасности для человека. В основном растет на деревьях, используется в производстве изысканных сыров. Внешний вид – налет синего цвета.
Серая
 Серые (сапрофитные) грибы выглядят как простой налет. Оседает почти на любых поверхностях и покрывает различные материалы. Иногда поражает еду (овощи, фрукты) и передается через цветочные семена.
Серые (сапрофитные) грибы выглядят как простой налет. Оседает почти на любых поверхностях и покрывает различные материалы. Иногда поражает еду (овощи, фрукты) и передается через цветочные семена.
Представляет опасность для человека, сложно выводится.
Почему появляется плесень?
Рассмотрим три обязательных условия для появления грибка:
- Наличие плесневых спор в воздухе. Попасть в дом могут с воздушным потоком, через вещи, продукты, на животных;
- Подпитывающая органическая среда: бумага, дерево, камень, бетон, грязь, торф, а также почва в горшках комнатных растений и др.;
- Климат, подходящий для роста и размножения. А именно:
- Температура около +20°С, влажность – 70-90%;
- Неравномерное отопление в помещении и плохая работа вентиляционной системы.
Голубая плесень. Голубые сыры

La Roche
Голубые сыры — группа сыров , имеющая зелено-голубоватый цвет сырной массы , который ей придаёт грибница благородной плесени (специальные виды плесени рода Penicillium , например Penicillium roqueforti или Penicillium glaucum ).
Для приготовления этих сыров творожную массу перед созреванием засевают спорами плесени и длинными иглами или иными способами проделывают воздушные каналы внутри сырной массы. Воздух даёт возможность голубой плесени развиться внутри сыра.
Плесень придаёт таким сырам особый островатый аромат.
По легенде, голубые сыры обязаны своим появлением на свет молодому пастуху, который при встрече со случайной незнакомкой так ею увлёкся, что забыл об обеде. Оставленный им в известковой пещере сыр оброс плесенью. Это печальное обстоятельство не помешало влюблённому впоследствии съесть с виду испорченный сыр и найти его вкус приятным.
Основная статья: Данаблю
Впервые сыр Данаблю выпустили еще в 1915 году на датском острове Фюн. На тот момент в Дании производилось уже немало разновидностей голубых сыров, и рецепт нового продукта тщательно обдумывали более десяти лет. Только в конце тридцатых годов была выработана стратегия производства Данаблю, определены состав, жирность молока, способ внедрения в сырный круг благородной плесени. Для равномерного роста последней необходимо много кислорода, поэтому сыроделам приходится изощряться и проделывать в сыре много отверстий с помощью специальных стальных спиц. Только когда плесень Penicillium roqueforti изнутри сырного круга прорастёт наружу и станет видна на корочке, Данаблю готов. Обычно на вызревание уходит не меньше месяца. Остается лишь вымыть и просушить сырные головки.
Голубой сыр в ремесленной традиции фермеров на севере Испании. Все молоко, используемое в производстве Кабраля, должно быть исключительно из стад в горной местности провинции Астурии .
Основная статья: Горгондзола
Один из наиболее известных итальянских сыров, отличающийся характерным островатым вкусом. Родиной сыра является Ломбардия , главное производство сыра сосредоточено в окрестностях Милана , Новары , Комо , Павии . Происхождение сыра датируется средними веками. Название происходит от небольшого городка близ Милана.
Виды плесени на хлебе. Опасные виды плесени на хлебе
Плесень на хлебе образуют различные виды грибков – небольших микроорганизмов, активно размножающихся в благоприятной для них среде. Разновидностей подобных структур достаточно много и формироваться они могут в различных условиях, как из-за неправильного хранения дома, так еще на этапе производства при несоблюдении строгих технических регламентов безопасности и технологичности.
Естественно, не имея под руками достаточно мощного микроскопа, невозможно установить в точности тип грибкового поражения продукта – видимые невооруженным глазом споры на поверхности имеют также микроскопические корни в толще изделия и визуально отличаются только цветом.

Помимо этого стоит учитывать и зону потенциального поражения – обычно она в несколько раз больше, чем внешний «налет», который видит человек. Как показывает клиническая практика, отдельные виды плесени являются более опасными для здоровья, нежели их «собратья».
- Черная плесень на хлебе . Наиболее опасный вид, зачастую имеющий выраженные токсические свойства. Оттенки могут варьироваться от насыщенно-серых и коричневых вплоть до угольно-темных. Обычно визуальную плесень этого вида формируют грибки рода Aspergillus и Fusarium;
- Зеленая плесень . Зеленую плесень может формировать огромное количество различных грибков, как токсических (например, Cladosporium), так и условно патогенных (например, микроорганизмы пенициллинового ряда);
- Желтая плесень . Встречается реже первых двух вариантов, обычно вызывается грибками Bipolaris и аналогами данного рода. Считается патогенной, наибольшее влияние оказывает на детей и пожилых людей (повышаются риски развития ряда заболевания), у здоровых взрослых индивидуумов при употреблении может вызывать диспепсическое расстройство;
- Синяя плесень . Данный вид плесени может указывать на наличие патогенных микроорганизмов (мицелий, актиномицетов), так и на колонию относительно безопасных «съедобных» видов грибков;
- Белая плесень . Белая плесень менее опасна для здоровья человека, чем предыдущие виды, но вызывающие её грибки могут выступать сильными аллергенами, вызывая соответствующие реакции, вплоть до аутоиммунных;
- Розовая плесень . Относительно безопасна для человека, проявляется обычно на белом пшеничном хлебе в виде пигментных пятне и вызывается «картофельной палочкой» – по сути, бактериями, но не грибками.
Белая плесень
Белая плесень тоже распространена, но, как правило, опасений вызывает гораздо меньше. Действительно, она менее опасна. Чаще всего белая плесень поражает почву (в том числе и ту, в которой обитают комнатные растения), деревья, различные растения, а также сыр и хлеб. Некоторые виды используются для изготовления благородных сыров. На фото грибки выглядят как белый налёт с множеством переплетений тончайших нитей.
Белая плесень представлена следующими штаммами:

Белая плесень
Sclerotinia – сумчатые грибы из рода дискомицетов, являющиеся возбудителями так называемой белой гнили. Они чаще всего поражают овощи и фрукты. Этот штамм может встречаться и на открытых пространствах, и в закрытых помещениях.- Aspergillus – высшие плесневые грибки, грибницы которых (без спор) окрашены в белый цвет.
- Serpula lacrymans. Часто его называют дымовым грибом. Хотя для людей такой вид опасности не представляет, но он является самым злейшим врагом деревянных конструкций (поэтому и обнаруживается чаще всего именно в деревянных зданиях).
- Эта белая плесень хоть и используется для изготовления антибиотиков, но патогенна и опасна для людей. Чаще всего данный грибок обнаруживается в почвах.
- Об этих грибках уже было написано выше.


 Какой бывает плесень?
Какой бывает плесень? Розовая
Розовая Белая
Белая Голубая
Голубая